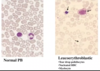
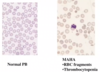

Haematology 6 - Haematology in systemic disease and intro to haematopathology Flashcards
(51 cards)
What disease is characterised by primary raised erythrocytes?
Polycythaemia vera
What disease is characterised by a secondary reduction in erythrocytes?
Auto-immune haemolytic anaemia
Which disease is caused by a genetic deficiency of factor IX?
Haemophilia B
Which disease is caused by a genetic excess of factor IX?
Factor IX Padua
How can haemophilia B be treated using gene therapy?
Factor IX Padua gene can be put into adenoviruses as a vector, to cause factor IX production
Which disease is caused by an acquired mutation in JAK2?
Polycythaemia vera
Which disease is caused by an acquired mutation in PIG A?
PNH paroxysmal nocturnal haemoglobinuria
What is a raised factor VIII likely to be secondary to?
An inflammatory process
may cause thrombosis (high F8)
How can haemophilia be acquired? (Rather than genetic)
Auto-immune disorder common in elderly - body produces autoantibodies directed against factor VIII
Recall 2 secondary causes of raised erythrocytes?
Altitude
EPO-secreting tumour
Recall 3 secondary causes of reduced erythrocytes
Bone marrow inflitration
Deficiency (B12/Fe)
Haemolytic anaemia
What is the most likely cause of iron deficiency anaemia?
Bleeding (until proven otherwise!)
How is iron deficiency anaemia diagnosed?
microcytic hypochromic anaemia
Low ferritin and transferrin saturation
High TIBC
What does an excess level of protein C lead to?
pro-thrombotic
Recall 3 types of cancer that may present first with an iron deficiency anaemia?
Gastric
Renal
Bladder
What are the morphological features of leuco-erythroblastic anaemia?
Erythroblasts (nucleated red blood cells and tear drop red blood cells)
Immature myeloid cells
What are the causes of leucoerythroblastic anaemia?
BM INFILTRATION
Malignancy: myelofibrosis/ leukaemia/lymphoma/myeloma/ metastatic Ca
Infection: miliary TB/severe fungal infection
What are the laboratory features of haemolytic anaemia?
Anaemia (though may be compensated)
Reticulocytosis
Unconjugated hyperbilirubinaemia
LDH raised (RBC breakdown)
Reduced haptoglobins
Causes of inherited haemolytic anaemia
Membrane – hereditary spherocytosis
Cytoplasm/enzyme – G6PD deficiency
Haemoglobin – SCD (structural) or thalassemia (quantitative)
Which test detects immune haemolytic anaemia?
DAT/Coombs
Causes of acquired haemolytic anaemia (immune mediated)
malignancy (lymphoma/CLL)
autoimmune (SLE)
infection (mycoplasma)
idiopathic
What would you see on blood film of someone with immune mediated haemolytic anaemia?
spherocytes (not hereditary spherocytosis)
Causes of acquired haemolytic anaemia (non immune mediated)
infection - malaria
microangiopathic anaemi
Recall 2 malignancies that can cause immune haemolytic anaemia?
Lymphoma
CLL